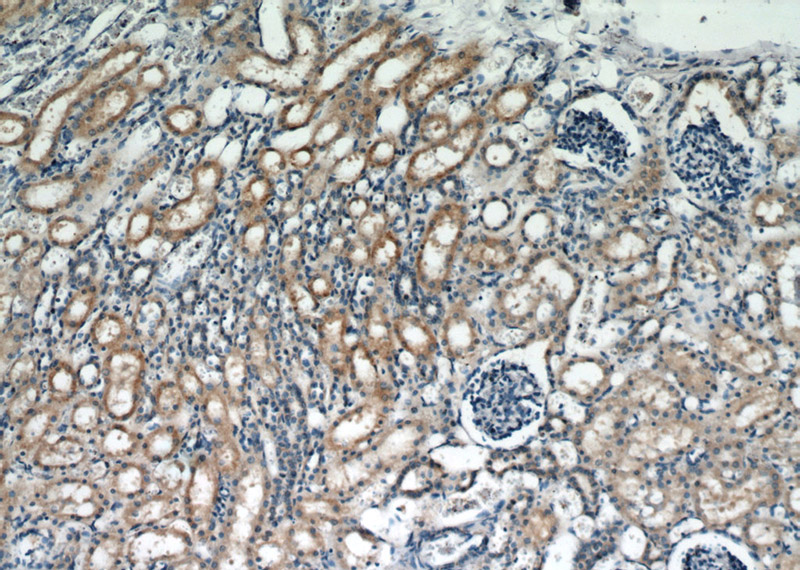
Immunohistochemical of paraffin-embedded human kidney using Catalog No:108370(BBS3 antibody) at dilution of 1:50 (under 10x lens)

-
Product Name
BBS3 antibody
- Documents
-
Description
BBS3 Rabbit Polyclonal antibody. Positive IHC detected in human kidney tissue, human brain tissue, human gliomas tissue. Positive IF detected in hTERT-RPE1 cells, MDCK cells. Positive IP detected in rat brain tissue. Positive WB detected in human brain tissue, HEK-293 cells, human testis tissue, mouse brain tissue, rat brain tissue. Observed molecular weight by Western-blot: 21 kDa
-
Tested applications
ELISA, IF, WB, IHC, IP
-
Species reactivity
Human,Mouse,Rat; other species not tested.
-
Alternative names
ADP ribosylation factor like 6 antibody; ARL6 antibody; BBS3 antibody
-
Isotype
Rabbit IgG
-
Preparation
This antibody was obtained by immunization of BBS3 recombinant protein (Accession Number: NM_032146). Purification method: Antigen affinity purified.
-
Clonality
Polyclonal
-
Formulation
PBS with 0.1% sodium azide and 50% glycerol pH 7.3.
-
Storage instructions
Store at -20℃. DO NOT ALIQUOT
-
Applications
Recommended Dilution:
WB: 1:200-1:2000
IP: 1:200-1:2000
IHC: 1:20-1:200
IF: 1:20-1:200
-
Validations

human brain tissue were subjected to SDS PAGE followed by western blot with Catalog No:108370(BBS3 antibody) at dilution of 1:500
Immunohistochemical of paraffin-embedded human kidney using Catalog No:108370(BBS3 antibody) at dilution of 1:50 (under 10x lens)

Immunohistochemical of paraffin-embedded human kidney using Catalog No:108370(BBS3 antibody) at dilution of 1:50 (under 40x lens)

IF result (cytoplasm and the base of cilia stain) of anti-BBS3 (Catalog No:108370; 1:50) with hTERT-RPE1 cell (MeOH fixed) by Dr. Moshe Kim.

IP Result of anti-BBS3 (IP:Catalog No:108370, 3ug; Detection:Catalog No:108370 1:600) with rat brain tissue lysate 5200ug.
-
Background
ADP-ribosylation factor-like protein 6 (ARL6), belongs to a small GTPase superfamily, is involved in membrane protein trafficking at the base of the ciliary organelle. ARL6 is also named Bardet-Biedl syndrome 3 protein, because defects in ARL6 are a cause of Bardet-Biedl syndrome type 3 (BBS3), which is a genetically heterogeneous disorder characterized by usually severe pigmentary retinopathy, early onset obesity, polydactyly, hypogenitalism, renal malformation and mental retardation. ARL6 can interact with many ARL6 interacting proteins and form BBSome complex with other BBS proteins including BBS1, BBS2, BBS4 and so on.
-
References
- Humbert MC, Weihbrecht K, Searby CC. ARL13B, PDE6D, and CEP164 form a functional network for INPP5E ciliary targeting. Proceedings of the National Academy of Sciences of the United States of America. 109(48):19691-6. 2012.
- Leitch CC, Lodh S, Prieto-Echagüe V, Badano JL, Zaghloul NA. Basal body proteins regulate Notch signaling through endosomal trafficking. Journal of cell science. 127(Pt 11):2407-19. 2014.
Related Products / Services
Please note: All products are "FOR RESEARCH USE ONLY AND ARE NOT INTENDED FOR DIAGNOSTIC OR THERAPEUTIC USE"
